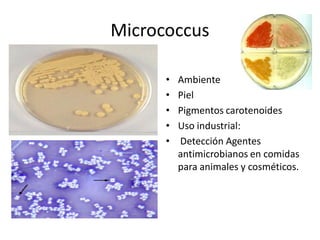
Micrococcus 

      •    Ambiente 
      •    Piel 
      •    Pigmentos carotenoides 
      •    Uso industrial: 
      •    Detección Agentes 
           antimicrobianos en comidas 
           para animales y cosméticos.
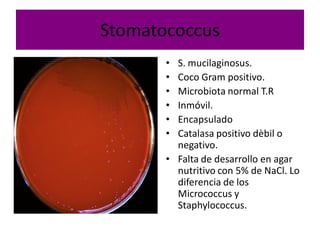
Stomatococcus 
       •  S. mucilaginosus. 
       •  Coco Gram positivo. 
       •  Microbiota normal T.R 
       •  Inmóvil. 
       •  Encapsulado 
       •  Catalasa positivo dèbil o 
          negativo. 
       •  Falta de desarrollo en agar 
          nutritivo con 5% de NaCl. Lo 
          diferencia de los 
          Micrococcus y 
          Staphylococcus.
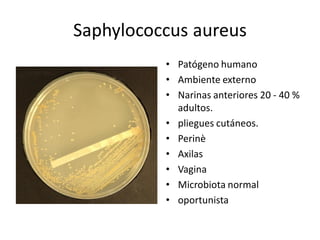
Saphylococcus aureus 
          •  Patógeno humano 
          •  Ambiente externo 
          •  Narinas anteriores 20 ‐ 40 % 
             adultos. 
          •  pliegues cutáneos. 
          •  Perinè 
          •  Axilas 
          •  Vagina 
          •  Microbiota normal 
          •  oportunista
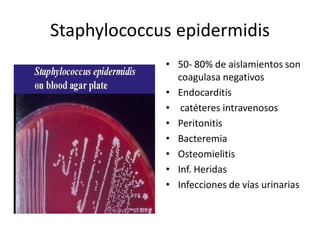
Staphylococcus epidermidis 
             •  50‐ 80% de aislamientos son 
                coagulasa negativos 
             •  Endocarditis 
             •  catéteres intravenosos 
             •  Peritonitis 
             •  Bacteremia 
             •  Osteomielitis 
             •  Inf. Heridas 
             •  Infecciones de vías urinarias
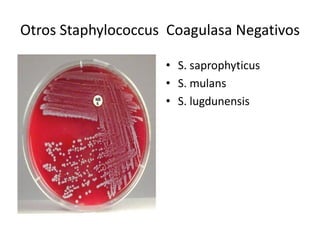
Otros Staphylococcus  Coagulasa Negativos 

                     •  S. saprophyticus 
                     •  S. mulans 
                     •  S. lugdunensis
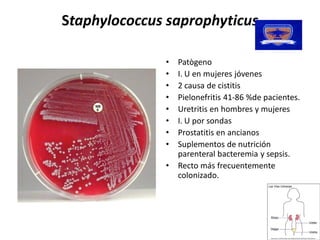
Staphylococcus 
 taphylococcus saprophyticus 

               •  Patògeno 
               •  I. U en mujeres jóvenes 
               •  2 causa de cistitis 
               •  Pielonefritis 41‐86 %de pacientes. 
               •  Uretritis en hombres y mujeres 
               •  I. U por sondas 
               •  Prostatitis en ancianos 
               •  Suplementos de nutrición 
                  parenteral bacteremia y sepsis. 
               •  Recto más frecuentemente 
                  colonizado.
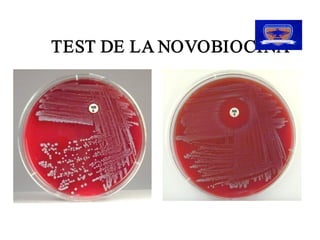
TEST DE LA NOVOBIOCINA
TEST DE LA NOVOBIOCINA
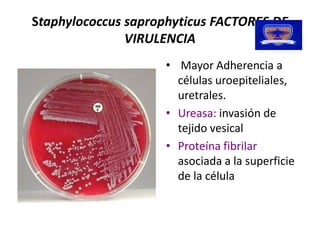
Staphylococcus saprophyticus 
               saprophyticus FACTORES DE 
               VIRULENCIA 
                     •  Mayor Adherencia a 
                        células uroepiteliales, 
                        uretrales. 
                     •  Ureasa: invasión de 
                        tejido vesical 
                     •  Proteína fibrilar 
                        asociada a la superficie 
                        de la célula
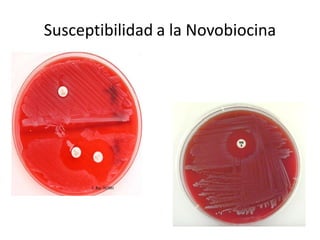
Susceptibilidad a la Novobiocina
Susceptibilidad a la Novobiocina
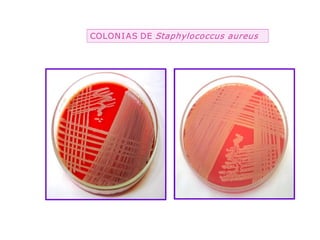
COLON I AS DE  Staphylococcus aureus 
               Staphylococcus aureus
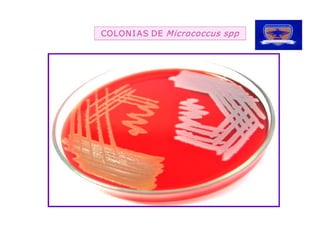
AS DE  Micrococcus spp
COLON I AS DE
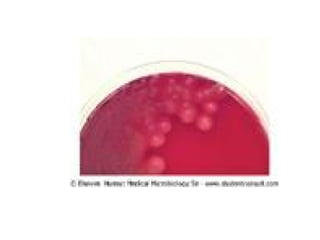
Familia Micrococaceae

Este documento describe varios géneros y especies de bacterias gram positivas, incluyendo Staphylococcus, Streptococcus, Micrococcus y Planococcus. Explica sus características, hábitats comunes, y su papel en diferentes enfermedades humanas como infecciones de la piel y sistémicas. También proporciona detalles sobre técnicas para identificar estas bacterias en el laboratorio.